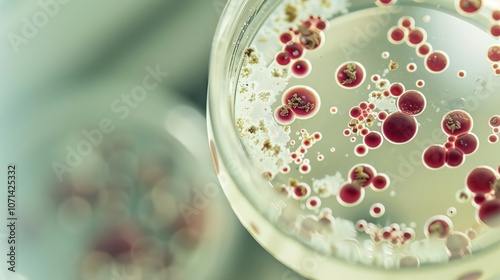

Close-up of microscope slide revealing intricate fungal spores, essential for research on fungal diseases and microbiology studies.
Keywords
fungal,
disease,
spore,
microscope,
laboratory,
biology,
science,
research,
study,
medicals,
health,
pathology,
fungal,
infection,
slide,
specimen,
investigation,
analysis,
experiment,
diagnostic,
mycology,
mobile phone,
organism,
equipment,
tool,
scientific,
observation,
exam